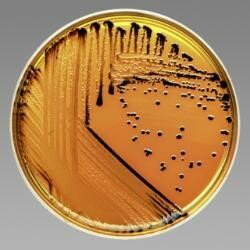
La pasteurización y el control en el laboratiorio

-
 En el año 1621 se publican las leyes de reflexión y refracción, dos fenómenos físicos de la óptica en los que se basa el microscopio, y el microscopio es uno de los elementos claves para la biología celular (imagen adjunta muestra los cristales que hay dentro de un microscopio y como deforman la luz)
En el año 1621 se publican las leyes de reflexión y refracción, dos fenómenos físicos de la óptica en los que se basa el microscopio, y el microscopio es uno de los elementos claves para la biología celular (imagen adjunta muestra los cristales que hay dentro de un microscopio y como deforman la luz) -
 La fotogrametría empezó como una técnica de cartografía/mapeado (matemática) que usa distintas imágenes en distintas posiciones y ángulos para crear un modelo en 3D, esta técnica se empezó a usar para volcar los datos del M.E.B. hacia una imagen 3D (imagen adjunta de un glóbulo rojo)
La fotogrametría empezó como una técnica de cartografía/mapeado (matemática) que usa distintas imágenes en distintas posiciones y ángulos para crear un modelo en 3D, esta técnica se empezó a usar para volcar los datos del M.E.B. hacia una imagen 3D (imagen adjunta de un glóbulo rojo) -
La técnica de pasteurización descubierta por el químico Luis Pasteur, descubierta en el año 1864, usa el proceso físico de la ebullición para controlar la población bacteriana y mantener estériles ciertos elementos cruciales en los laboratorios y evitar la contaminación en cultivos bacterianos. (imagen adjunta de un cultivo bacteriano sobre una placa previamente esterilizada)
La técnica de pasteurización descubierta por el químico Luis Pasteur, descubierta en el año 1864, usa el proceso físico de la ebullición para controlar la población bacteriana y mantener estériles ciertos elementos cruciales en los laboratorios y evitar la contaminación en cultivos bacterianos. (imagen adjunta de un cultivo bacteriano sobre una placa previamente esterilizada) -
 El azul de metileno se sintetizó por primera vez en el año 1876, como un tinte hecho a base de anilina, inicialmente usado para en la industria textil, pero luego los científicos Robert Koch y Paul Elrich vieron su potencial para la microscopia y para diversos usos más como el tratamiento de la malaria y antiséptico (adjunta imagen de la composición química del azul metileno)
El azul de metileno se sintetizó por primera vez en el año 1876, como un tinte hecho a base de anilina, inicialmente usado para en la industria textil, pero luego los científicos Robert Koch y Paul Elrich vieron su potencial para la microscopia y para diversos usos más como el tratamiento de la malaria y antiséptico (adjunta imagen de la composición química del azul metileno) -
 Una técnica creada en el año 1912 por el físico Max Von Laude, esta técnica usada para el estudio de materiales se basa en el concepto de difracción de los rayos x sobre un cristal. Esta técnica ayudó a determinar las propiedades estructurales de proteínas y componentes celulares (foto adjunta de la doble helice del ADN, imagen creada con esta tecnica)
Una técnica creada en el año 1912 por el físico Max Von Laude, esta técnica usada para el estudio de materiales se basa en el concepto de difracción de los rayos x sobre un cristal. Esta técnica ayudó a determinar las propiedades estructurales de proteínas y componentes celulares (foto adjunta de la doble helice del ADN, imagen creada con esta tecnica)
Looking for a timeline maker?
Create timelines for projects, roadmaps, history, lessons, legal cases, and stories with Timetoast. Timetoast is a timeline maker for work, school, research, and stories.